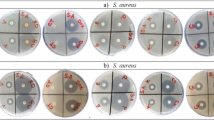

Abstract
Replying to: W. Balemans et al. Nature 462, 10.1038/nature08667 (2009)
Our studies led us to conclude that growth of major Gram-positive pathogens, including Staphylococcus aureus, is not inhibited by FASII-targeted antibiotics in septicaemic infection, owing to compensation by serum fatty acids1. The comments of Balemans et al.2 challenge the generality of our results, mainly on the basis of their own work, which is aimed at developing FabI inhibitors for treatment of S. aureus infections. Their allusion to the documented use of FASII inhibitors to treat mycobacterial infections is misleading. Mycobacteria were not considered in our study, because (1) their main route of pathogenesis is not sepsis, and (2) they require mycolic acids for normal growth, which are lacking in serum. The results we present here further reinforce the conclusions of our article.
Similar content being viewed by others
Enjoying our latest content?
Log in or create an account to continue
- Access the most recent journalism from Nature's award-winning team
- Explore the latest features & opinion covering groundbreaking research
or
References
Brinster, S. et al. Type II fatty acid synthesis is not a suitable antibiotic target for Gram-positive pathogens. Nature 458, 83–86 (2009)
Balemans, W. et al. Essentiality of FASII pathway for Staphylococcus aureus . Nature 462, 10.1038/nature08668 (this issue)
Heath, R. J. & Rock, C. O. Fatty acid biosynthesis as a target for novel antibacterials. Curr. Opin. Investig. Drugs 5, 146–153 (2004)
Altenbern, R. A. Cerulenin-inhibited cells of Staphylococcus aureus resume growth when supplemented with either a saturated or an unsaturated fatty acid. Antimicrob. Agents Chemother. 11, 574–576 (1977)
Weerkamp, A. & Vogels, G. D. Physiological conditions affecting Staphylococcus aureus susceptibility to staphylococcin 1580. Antimicrob. Agents Chemother. 13, 146–153 (1978)
Author information
Authors and Affiliations
PowerPoint slides
Rights and permissions
About this article
Cite this article
Brinster, S., Lamberet, G., Staels, B. et al. Brinster et al. reply. Nature 463, E4 (2010). https://doi.org/10.1038/nature08668
Issue date:
DOI: https://doi.org/10.1038/nature08668
This article is cited by
-
Staphylococcus epidermidis biofilm assembly and self-dispersion: bacteria and matrix dynamics
International Microbiology (2023)
-
Environmental fatty acids enable emergence of infectious Staphylococcus aureus resistant to FASII-targeted antimicrobials
Nature Communications (2016)